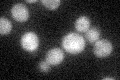
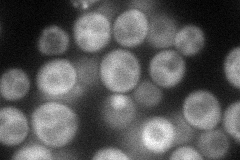
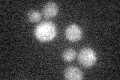

View description
Co-chaperone that stimulates the ATPase activity of Ssa1p, required for a late step of ribosome biogenesis; associated with the cytosolic large ribosomal subunit; contains a J-domain; mutation causes defects in fluid-phase endocytosis
Localization:
Intensity:
Fold change:
Significance:
-
C’ GFP library in SD
cytosol27.69 -
N' NOP1pr-GFP in SD
cytosol63.6474 -
N' TEF2pr-mCherry in SD

cytosol85.8101 -
N' NATIVEpr-GFP in SD

cytosol26.9173 -
N' TEF2pr-VC and Cyto-VN in SD

cytosol29.8458 -
C’ GFP library in SD+DTT

cytosol25.260.91No -
C’ GFP library in SD+H2O2

cytosol25.610.92No -
C’ GFP library in Starvation Media
cytosol19.040.68No -
C’ GFP library on the background of Pup2-DaMP

cytosol -
C’ GFP library on the background of CCT mutant

cytosol30.79341.11178No
